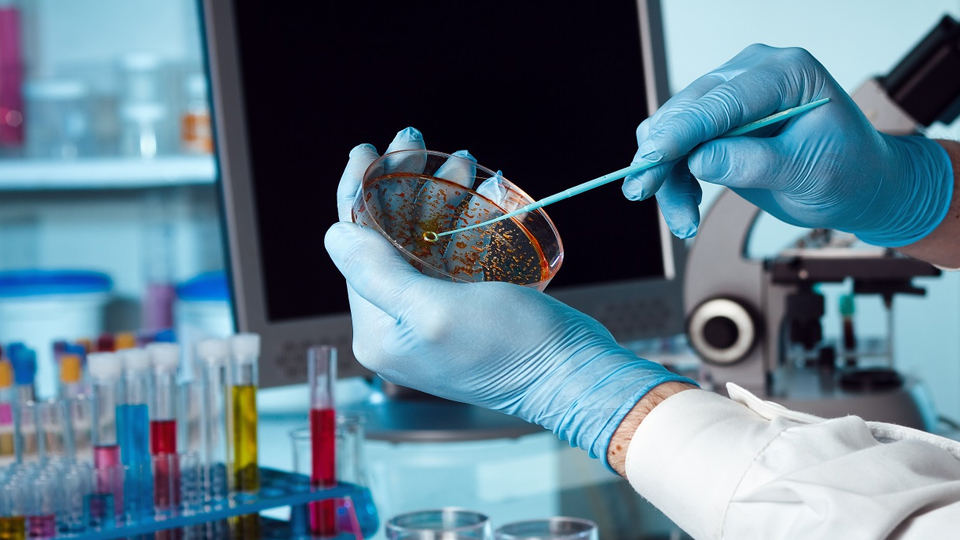

OUR SERVICES
Our Diagnostic Facilities
Biochemistry is the scientific study of the chemical and physical processes that occur within living
Read More
Hematology is the branch of medicine that deals with the study of blood & blood-forming tissues
Read More
Real-time polymerase chain reaction (PCR) is a technique used in molecular biology to detect
Read More
Cytopathology is the study of cells and their abnormalities, and it is a branch of pathology. It involves
Read More
Histopathology is the study of tissues and organs under a microscope to identify disease or abnormalities.
Read More
Molecular biology is a branch of biology that deals with the study of the molecular basis of biological
Read More
Clinical pathology is a medical specialty that focuses on the laboratory analysis of bodily fluids and
Read More
Sono Mammography, also known as breast ultrasound or breast sonography, is a medical imaging
Read More
Ultrasonography (USG) is a medical imaging technique that uses high-frequency sound waves to
Read More
Color Doppler is a medical imaging technique that uses ultrasound to visualize the flow of blood through
Read More
The Treadmill Test (TMT), also known as the Exercise Stress Test (EST), is a medical test that evaluates
Read More
A Pulmonary Function Test (PFT) is a type of medical test that measures how well the lungs are functioning.
Read More
Patient First Approach
Prioritizes the needs and well-being of the patient above all else
Modern Equipment
Advanced tools & technology that are designed to improve efficiency & accuracy
Highly Experienced Pathologists
Expertise in diagnosing diseases through the examination of tissue & bodily fluids
Instant Checkup & Appointment
Ability to schedule a medical consultation or examination immediately and without delay
Years of Experience
0Qualified Doctors
0Available Facilities
0Happy Patients
0Feedback

Kunali D
Have been visiting this lab for years, and I can confidently say they are the most efficient diagnostic centres I have seen. They are punctual to appointments, do bloodwork gently and calmly, and provide results fast. Trusted by my whole family, we 100% recommend this lab!

Hema Dave
The facility is equipped to perform a variety of pathology, cardiology and radiology evaluations, very convenient one-stop shop. Staff is very helpful, knowledgeable and professional. The owner, Mrs. Kashmira Choksey, is highly professional and smart individual with an extremely kind and caring attribute. My 80-year old mother had an extremely comfortable experience during her medical evaluations at Kashmira Diagnostic Center. Highly highly recommendable center.

Ramesh Bhambore
Best patholgy lab in borivali west on time report staff very cooperative

Ankita Borban
Excellent work done by kashmira team very supportive and happy with having consultations

Alita Dsouza
I can say the tests done here helped me immensely to actually detect and overcome an ailment. Immensely grateful to Kashmira Diagnostics.

Allwyn Dever
Prompt and professional Pathology Laboratory & Diagnostic Center
I Visited for my ECG test and felt really overwhelmed bu the amazing Service and timely delivered of report as promised by lab Incharge Dr. Kashmira
It's So reliving to experience such service in really needed time to any patient in their required times
all the best to lab team i wish them the best of service to everyone as we received from Kashmira Diagnostic Centre Pathology Lab

Hitesh Dave
Prompt and hassle free service. Kashmira did take care of all the details and explained the tests very well.
Online Appointment
Make An Appointment
Tie ups with Insurance agencies